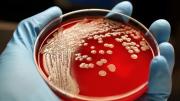
Qué es la toxina Cereulida y por qué es tan peligrosa para las personas

Local
06 de enero de 2026 Página 6
Aunque las pastas, en la mayoría de los casos, se consumen calientes, el calor de esta época lleva a variantes innovadoras. Y una de ellas es la pasta “corta” de verano.Se trata de un truco que propone el cocinero italiano Donato De Santis para comerla fría. En realidad,... + más

El fiscal federal Carlos Stornelli solicitó al juez Sebastián Ramos que se de comienzo a los trámites de extradición de Nicolas Maduro con el fin de que preste declaración indagatoria en Argentina. Según el documento al que accedió Todo Noticias, la decisión de Stornelli... + más
La relación de D'Alessio con Stornelli era un activo importante para la asociación criminal | Página 12
La Corte desvinculó a Stornelli del caso D’Alessio y allanó el juicio “Cuadernos” | El Destape
Rodrigo Atencio jugará en Newell’s la próxima temporada. El ex Central Córdoba de Santiago del Estero, confeso hincha leproso, logró un acuerdo en Brasil con Sport Recife para venir a préstamo un año al parque Independencia. La dirigencia rojinegra también hizo avances... + más

El fuerte temporal que azotó la ciudad de Neuquén este lunes dejó algunas de las consecuencias típicas de las tormentas de verano, que son cada vez más comunes en la región. Desde la Municipalidad, afirmaron que la ciudad respondió bien y que las obras pluviales han... + más
Aniversario de Neuquén: las mejores fotos del desfile | LMNeuquen
Neuquén se transforma en la Capital Navideña: un diciembre de magia, arte y reencuentro | Diario Río Negro
La ANSES informó el cronograma de pagos para este martes 6 de enero para jubilaciones, pensiones, AUH, AUE, prestaciones del SUAF y otros pagos. Cobran hoy:Leé también: La ANSES definió el cronograma de pagos de enero para jubilados, AUH y otras asignaciones: cuándo... + más
Bruno Mars dio la noticia que todos fans esperaban: confirmó que acaba de finalizar un nuevo disco. Desde hace casi diez años, no lanzaba un álbum y todo indica que el 2026 marcará su regreso.Aún no se conocen detalles como el título, portada o fecha de lanzamiento, pero... + más

La popular Cuenta DNI del Banco Provincia (BAPRO) ofrece este mes una variedad de descuentos en diversos rubros, que van desde bufetes de universidades y librerías hasta comercios de barrio y perfumerías, pero entre todos ellos sobresalen las ofertas en supermercados por su... + más
ANSES definió el calendario de pagos de enero 2026: cuándo cobran jubilados, AUH y planes sociales | Perfil
Calendario de pagos ANSES noviembre 2025: jubilaciones, pensiones y asignaciones | Perfil
El reciente retiro preventivo de un producto de Nestlé Argentina volvió a poner en agenda un término poco conocido fuera del ámbito científico: la toxina cereulida. La medida, comunicada por autoridades sanitarias nacionales, apuntó a evitar riesgos ante la posible... + más
Un incendio intencional desatado al amanecer del lunes destruyó las instalaciones del colegio Ave María, perteneciente a la obra de Don Orione, en la localidad de Claypole, partido de Almirante Brown.La comunidad orionita comenzó una campaña de recaudación de fondos a... + más

Las ventas de los comercios minoristas pymes por la llegada de los Reyes Magos 2026 crecieron 0,5% frente a la misma fecha de 2025, medidas a precios constantes. La fecha reflejó un consumo débil y fragmentado, con escaso movimiento generalizado y resultados inferiores a la... + más
Día de los Reyes Magos: el verdadero origen de la tradición, los regalos y los misterios que pocos conocen | Big Bang News
La Justicia federal avanzó este lunes con un nuevo paso en la causa que investiga presuntas violaciones a los derechos humanos cometidas por Nicolás Maduro. El fiscal Stornelli requirió formalmente su extradición a la Argentina con el objetivo de que sea indagado en el... + más

El Servicio Meteorológico Nacional prevé una jornada con cielo algo nublado y vientos intensos, mientras que para el miércoles se esperan tormentas hacia la tarde y la noche. Hoy 05:48 Según el Servicio Meteorológico Nacional, este martes 6 de enero Santiago del Estero... + más
Los costos del transporte de cargas, un factor fundamental para el traslado de granos en plena cosecha gruesa, acumularon una suba del 37,03% en 2025, tras registrar un incremento mensual de 2,3% en diciembre, según lo informado por la Federación Argentina de Entidades... + más
La crisis que atraviesa SanCor no responde a una única causa. Pero una de las claves pasa por la deuda millonaria que tiene Venezuela, país que hoy se encuentra en el centro de la atención mundial tras la captura del polémico mandatario Nicolás Maduro por parte de Estados... + más
“Ese fue el verdadero debut de la banda, porque hasta ese momento no habíamos hecho más que boludear. Y suponía un bautismo de fuego: era la primera vez que íbamos a tocar delante de un público que no estaba compuesto por amigotes”. Con esa contundente frase, describe... + más
Una influencer neuquina pasó por un infierno tras quedarse varada en Puerto Patriada, en la costa del lago Epuyén, por un gigantesco incendio forestal, que azota a la provincia de Chubut y aun no ha sido controlado. Se trata de Jael Queipo, una influencer de 26 años, quien... + más
En vivo | Diario Río Negro
El dramático testimonio de una familia que perdió todo en el incendio de Puerto Patriada | Diario Río Negro

Capital Navideña 2025 tendrá un final a lo grande. Este martes, desde las 21, en la explanada del monumento a San Martín, vecinos, vecinas y turistas podrán disfrutar de los espectáculos y sacarse la tradicional foto con el arbolito, antes de que se apaguen sus luces y deje... + más
El presidente Javier Milei aceptó la renuncia de Nélida Agustina Bisio como Administradora Nacional de la ANMAT y designó en su lugar al doctor Luis Eduardo Fontana, mediante el Decreto 3/2026, publicado este martes en el Boletín Oficial. La medida rige desde el 5 de enero... + más
Renunció la jefa de la ANMAT y la reemplaza el ex titular de la prepaga OSDE | Diario Panorama
Oficializan a Luis Fontana como titular de la ANMAT tras la salida de Bisio | El Liberal

Institucionales El sistema de internación domiciliaria bonaerense despertó el interés de las autoridades de Paraguay Miembros de la Cámara de Empresas de Internación Domiciliaria provincial fueron invitados por el ministerio de Salud paraguayo para exponer sobre los... + más
Ventajas de la internación domiciliaria | Perfil
Preocupación por el último parte médico de Miguel Ángel Russo: ¿cómo sigue su salud? | 0221
Una nueva denuncia por el estado de la Ruta Nacional 151 volvió a encender las alarmas por la seguridad vial en uno de los caminos más transitados de la Patagonia. Una vecina de Plottier que regresaba desde Mendoza advirtió que el tramo ubicado en la provincia de La Pampa,... + más

La Plata Alak y Katopodis coordinan acciones para preservar la Catedral de La Plata El intendente de La Plata y el ministro de Infraestructura bonaerense encabezaron una reunión de trabajo junto a autoridades eclesiásticas para avanzar en una agenda común de mantenimiento y... + más
Derrota de Julio Alak y La Cámpora en La Plata, que no movilizaron por Jorge Taiana | 0221

La vivienda de barrio Villa Serrana, en Córdoba, donde Pablo Laurta asesinó a su expareja Luna Giardina (24) y a su exsuegra Mariel Zamudio, fue víctima de tres robos consecutivos. La denuncia la realizó Laura Giardina, hermana de la joven asesinada, quien expresó su... + más

Un incendio forestal que avanza sin control en las inmediaciones de Cholila encendió las alarmas en toda la Comarca Andina de Chubut. Desde la tarde del domingo, brigadistas y bomberos trabajan contrarreloj para contener un frente ígneo que obligó a evacuar sectores rurales... + más
Los peores incendios en los últimos 20 años | Página 12
Los incendios forestales en Chubut continúan y se complican las tareas para frenar el fuego | Ámbito
Durante su presentación en la feria de tecnología CES 2026, Meta anunció buenas y malas noticias relacionadas con sus gafas inteligentes. Por un lado, la compañía de Mark Zuckerberg informó que se vio en la obligación de pausar la venta de las Ray-Ban Display en mercados... + más
Notibol. Desde 2006. Central de Noticias.
Notibol es un agregador informático de noticias y no es responsable del contenido de los enlaces a los sitios externos que generan las noticias.
Acerca de Notibol | Contacto | Política de Privacidad | Descargo de Responsabilidad